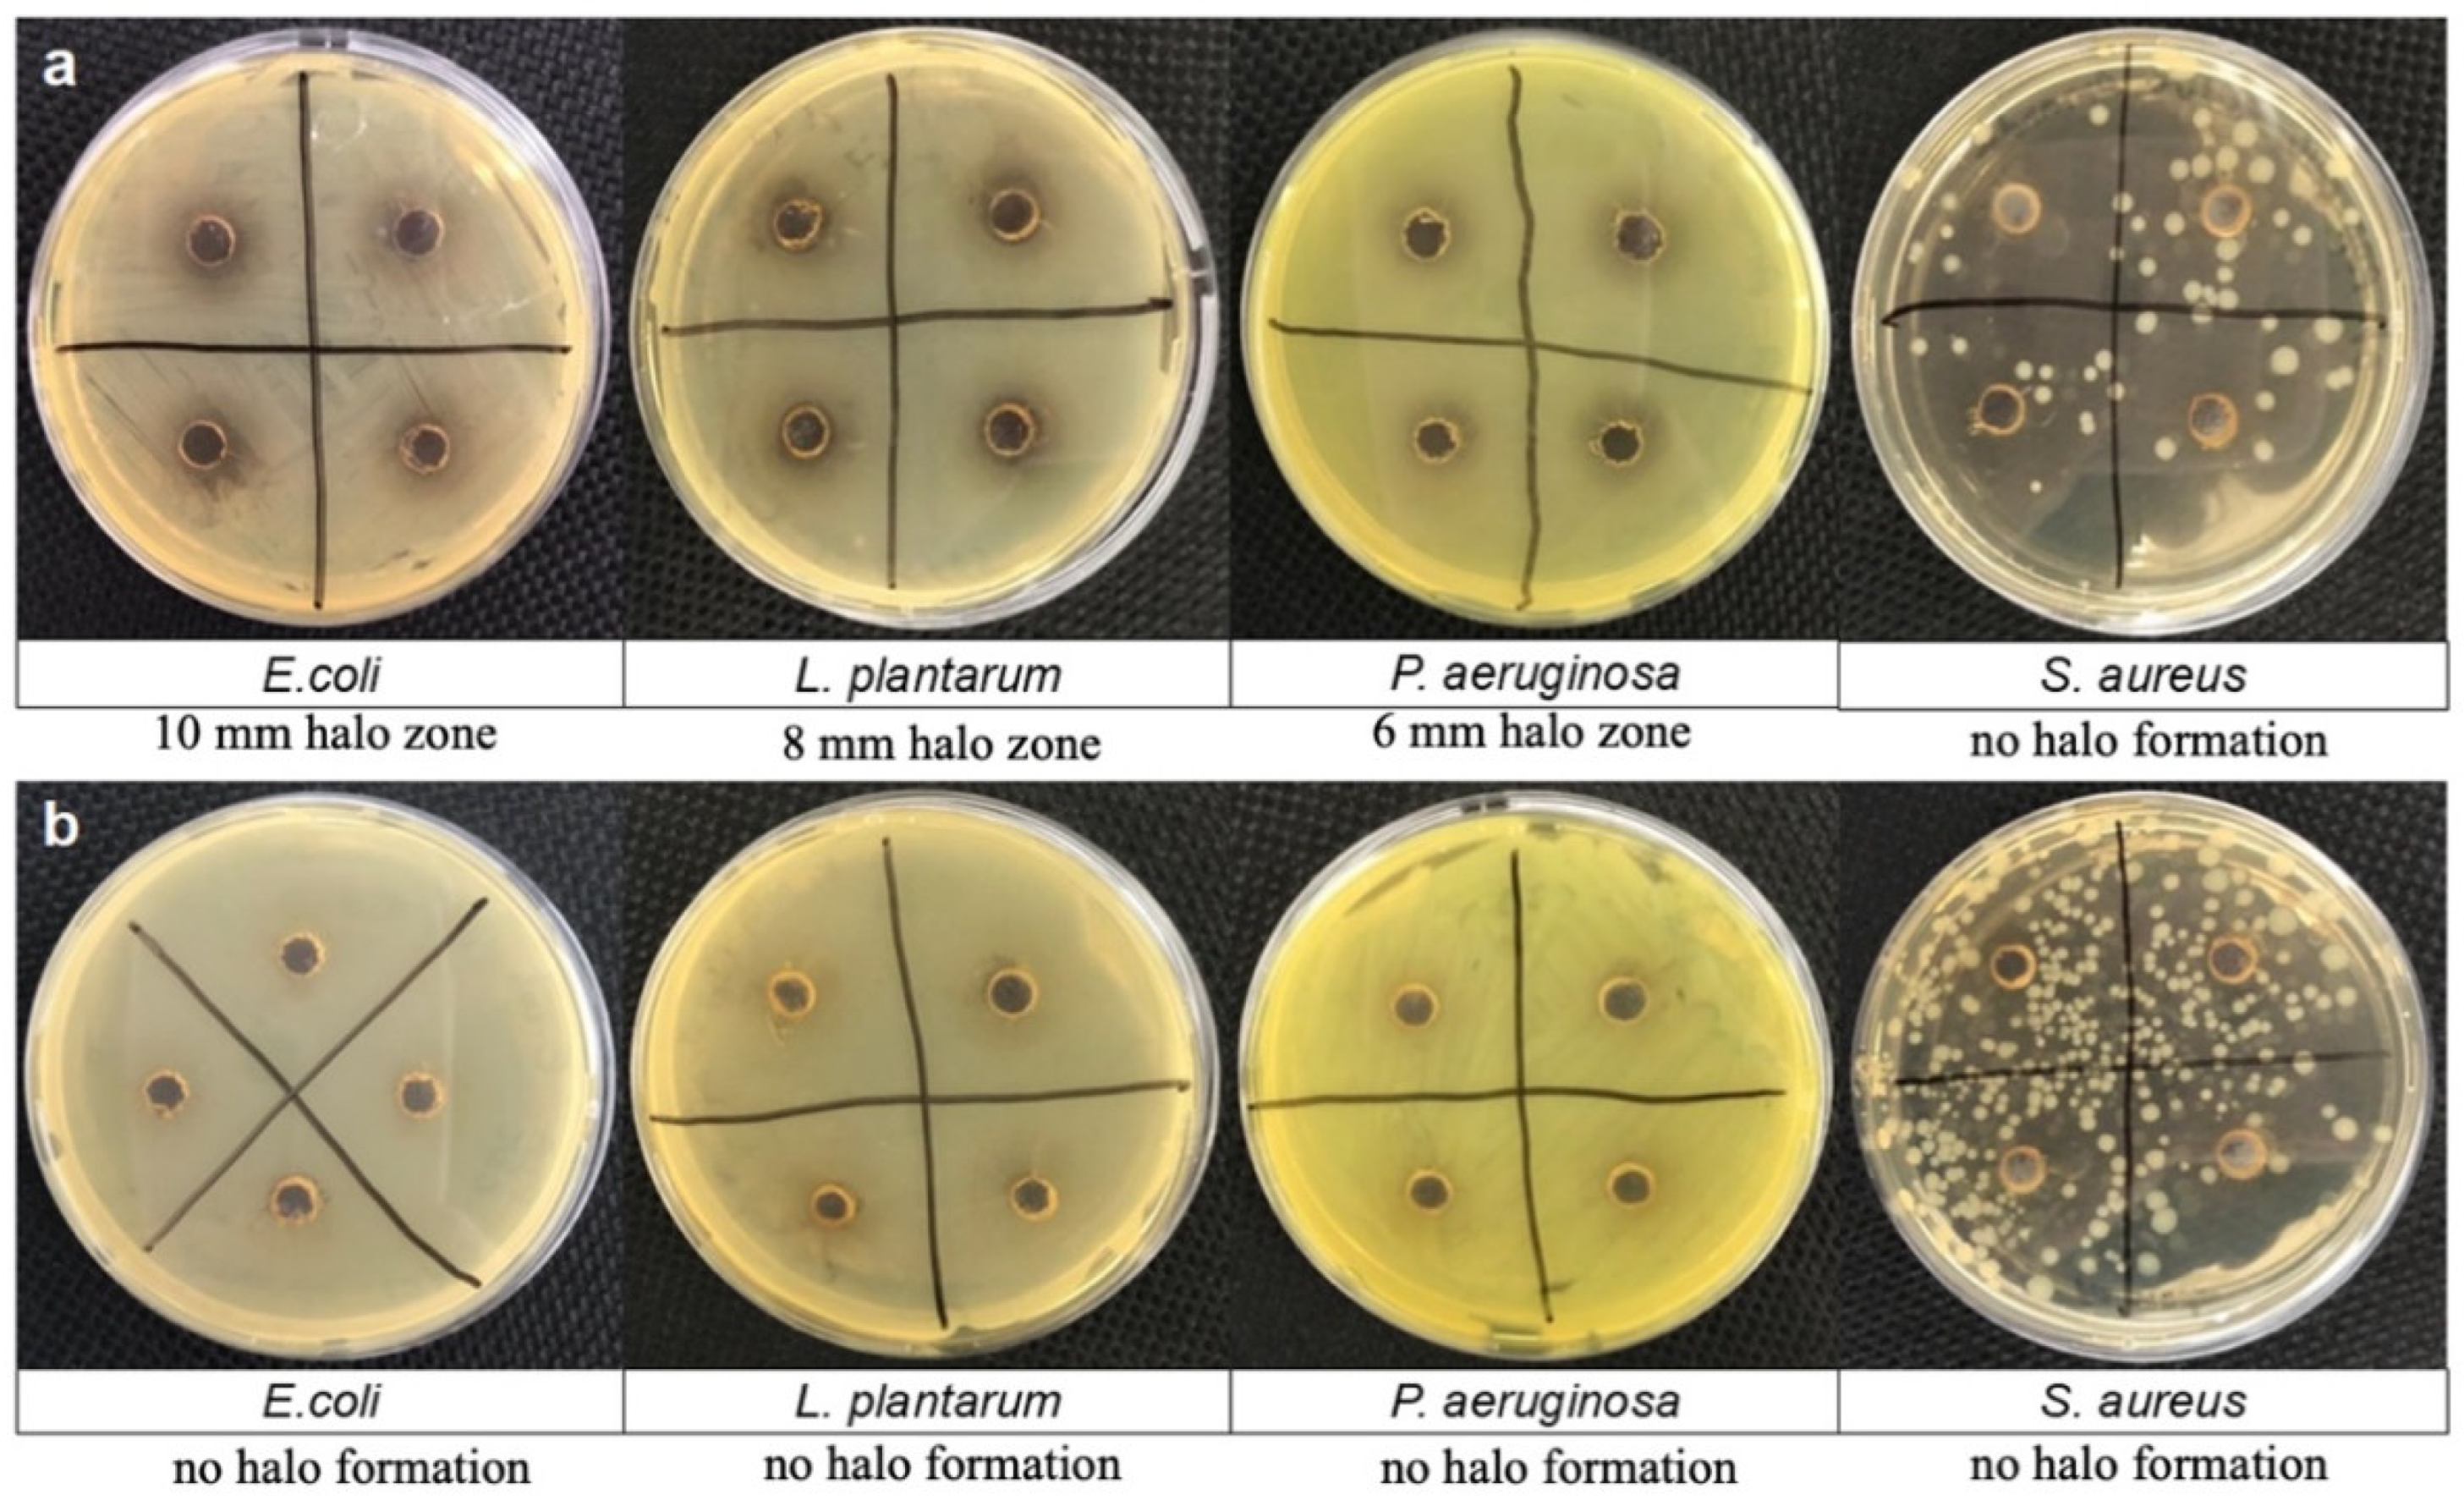
Polymers 17 00345 g005

Experimental and Theoretical Analysis of Dopamine Polymerization on the Surface of Cellulose Nanocrystals and Its Reinforcing Properties in Cellulose Acetate Films
Abstract
1. Introduction
2. Materials and Methods
2.1. Materials
2.2. Preparation of Cellulose Nanocrystals (CNCs) Coated with Polydopamine (CNC@PDA)
2.3. Characterization of CNC@PDA
2.4. Investigation of the Antimicrobial Activity of Polydopamine Solution and CNC@PDA Suspension
Agar Diffusion Plate Method
2.5. Production and Mechanical Characterization of Cellulose Acetate-Based Films Using CNC@PDA
Mechanical Properties Analysis
2.6. Statistical Analysis
3. Results and Discussion
3.1. Preparation and Characterization of CNC@PDA Suspensions
- (1)
- Protonated primary amine: At this lower pH, dopamine’s primary amine is protonated. This means that it has captured a hydrogen ion (H⁺) from the solution, becoming positively charged (dopamine semiquinone). This is because, in acidic or slightly neutral environments, amines generally accept protons and become protonated. In other words, the protonated form is dominant because the pH is below the pKa of the primary amine.
- (2)
- Undissociated hydroxyl groups: While the amine is protonated, the hydroxyl groups (–OH) in dopamine are not dissociated. Dissociation, in this context, refers to the separation of a hydrogen from the hydroxyl group, forming phenoxide ions (–O−). At a pH below 8.5, these hydroxyl groups remain in their original form and do not dissociate (dopamine semiquinone).
- (3)
- Transition ≈ pH 8.5: As the pH of the solution increases and approaches 8.5, the environment becomes more alkaline. At this higher pH, the hydroxyl group of dopamine, which is more acidic than the amine, begins to dissociate (dopamine quinone). This means that the hydroxyl group can lose a hydrogen ion, forming phenoxide ions (–O−) in the solution.
- (4)
- Equilibrium: When the pH is close to 8.5, an equilibrium is established between the protonated form of the amine and the dissociation of the hydroxyl group. This means that, from this point onwards, both the protonated form of the amine and the dissociated hydroxyl groups coexist in a proportion determined by the pH of the solution.
3.2. ζ Potential
3.3. Fourier-Transformed Infrared Spectroscopy (FTIR)
3.4. Thermogravimetric Analysis (TGA)
3.5. Investigation of the Antimicrobial Activity of PDA Solution and CNC@PDA Suspensions
3.6. Mechanical Properties
4. Conclusions
Author Contributions
Funding
Data Availability Statement
Conflicts of Interest
Abbreviations
| CNCs | Cellulose nanocrystals |
| PDA | Polydopamine |
| CNC@PDA | PDA-coated CNC |
| ROS | Reactive oxygen species |
| AC | Cellulose acetate |
| PVA | Polyvinyl alcohol |
| PEG | Polyethylene glycol |
| SEM | Scanning electron microscopy |
| FTIR | Fourier-transformed infrared absorption spectroscopy |
| TGA | Thermogravimetric analysis |
| PDI | Polydispersity index |
| DLS | Dynamic light scattering |
| ATR | Attenuated reflectance |
References
- Bai, L.; Ding, A.; Li, G.; Liang, H. Application of Cellulose Nanocrystals in Water Treatment Membranes: A Review. Chemosphere 2022, 308, 136426. [Google Scholar] [CrossRef] [PubMed]
- Mali, P.; Sherje, A.P. Cellulose Nanocrystals: Fundamentals and Biomedical Applications. Carbohydr. Polym. 2022, 275, 118668. [Google Scholar] [CrossRef] [PubMed]
- Alarcón-Moyano, J.; Acuña, D.; Matiacevich, S.; Caballero, L.; Melo, F.; Quero, F.; Díaz-Calderón, P. Physico-Chemical and Structural Characterization of Cellulose Nanocrystals Obtained by Two Drying Methods: Freeze-Drying and Spray-Drying. Food Hydrocoll. 2023, 140, 108571. [Google Scholar] [CrossRef]
- Tian, W.; Gao, X.; Zhang, J.; Yu, J.; Zhang, J. Cellulose Nanosphere: Preparation and Applications of the Novel Nanocellulose. Carbohydr. Polym. 2022, 277, 118863. [Google Scholar] [CrossRef] [PubMed]
- Ilyas, R.A.; Sapuan, S.M.; Ishak, M.R.; Zainudin, E.S. Effect of Delignification on the Physical, Thermal, Chemical, and Structural Properties of Sugar Palm Fibre. Bioresources 2017, 12, 8734–8754. [Google Scholar] [CrossRef]
- Ridzuan, M.J.M.; Abdul Majid, M.S.; Afendi, M.; Aqmariah Kanafiah, S.N.; Zahri, J.M.; Gibson, A.G. Characterisation of Natural Cellulosic Fibre from Pennisetum Purpureum Stem as Potential Reinforcement of Polymer Composites. Mater. Des. 2016, 89, 839–847. [Google Scholar] [CrossRef]
- Su, Y.; Zhao, Y.; Zhang, H.; Feng, X.; Shi, L.; Fang, J. Polydopamine Functionalized Transparent Conductive Cellulose Nanopaper with Long-Term Durability. J. Mater. Chem. C Mater. 2017, 5, 573–581. [Google Scholar] [CrossRef]
- Liu, S.; Chen, Y.; Liu, C.; Gan, L.; Ma, X.; Huang, J. Polydopamine-Coated Cellulose Nanocrystals as an Active Ingredient in Poly(Vinyl Alcohol) Films towards Intensifying Packaging Application Potential. Cellulose 2019, 26, 9599–9612. [Google Scholar] [CrossRef]
- Szewczyk, J.; Aguilar-Ferrer, D.; Coy, E. Polydopamine Films: Electrochemical Growth and Sensing Applications. Eur. Polym. J. 2022, 174, 111346. [Google Scholar] [CrossRef]
- Wu, J.; Zhang, L.; Wang, Y.; Long, Y.; Gao, H.; Zhang, X.; Zhao, N.; Cai, Y.; Xu, J. Mussel-Inspired Chemistry for Robust and Surface-Modifiable Multilayer Films. Langmuir 2011, 27, 13684–13691. [Google Scholar] [CrossRef]
- Shang, Q.; Liu, C.; Hu, Y.; Jia, P.; Hu, L.; Zhou, Y. Bio-Inspired Hydrophobic Modification of Cellulose Nanocrystals with Castor Oil. Carbohydr. Polym. 2018, 191, 168–175. [Google Scholar] [CrossRef] [PubMed]
- Xu, Y.; Zheng, D.; Chen, X.; Yao, W.; Wang, Y.; Zheng, Z.; Tan, H.; Zhang, Y. Mussel-Inspired Polydopamine-Modified Cellulose Nanocrystal Fillers for the Preparation of Reinforced and UV-Shielding Poly (Lactic Acid) Films. J. Mater. Res. Technol. 2022, 19, 4350–4359. [Google Scholar] [CrossRef]
- Zheng, T.; Clemons, C.M.; Pilla, S. Grafting PEG on Cellulose Nanocrystals via Polydopamine Chemistry and the Effects of PEG Graft Length on the Mechanical Performance of Composite Film. Carbohydr. Polym. 2021, 271, 118405. [Google Scholar] [CrossRef]
- Nagamine, S.; Mizuno, Y.; Hikima, Y.; Okada, K.; Wang, L.; Ohshima, M. Reinforcement of Polypropylene by Cellulose Microfibers Modified with Polydopamine and Octadecylamine. J. Appl. Polym. Sci. 2021, 138, 49851. [Google Scholar] [CrossRef]
- Galván, Z.R.N.; Soares, L.d.S.; Medeiros, E.A.A.; Soares, N.d.F.F.; Ramos, A.M.; Coimbra, J.S.d.R.; de Oliveira, E.B. Rheological Properties of Aqueous Dispersions of Xanthan Gum Containing Different Chloride Salts Are Impacted by Both Sizes and Net Electric Charges of the Cations. Food Biophys. 2018, 13, 186–197. [Google Scholar] [CrossRef]
- Soares, L.D.S.; Perim, R.B.; de Alvarenga, E.S.; Guimarães, L.D.M.; Teixeira, A.V.N.D.C.; dos Reis Coimbra, J.S.; de Oliveira, E.B. Insights on Physicochemical Aspects of Chitosan Dispersion in Aqueous Solutions of Acetic, Glycolic, Propionic or Lactic Acid. Int. J. Biol. Macromol. 2019, 128, 140–148. [Google Scholar] [CrossRef]
- Clinical and Laboratory Standards Institute. Performance Standards for Antimicrobial Susceptibility Testing: Twenty-Second Informational Supplement. Wayne 2015, 5, 4. [Google Scholar]
- Soares, N.F.F.; Hotchkiss, J.H. Naringinase Immobilization in Packaging Films for Reducing Naringin Concentration in Grapefruit Juice. J. Food Sci. 1998, 63, 61–65. [Google Scholar] [CrossRef]
- Palladino, P.; Bettazzi, F.; Scarano, S. Polydopamine: Surface Coating, Molecular Imprinting, and Electrochemistry—Successful Applications and Future Perspectives in (Bio)Analysis. Anal. Bioanal. Chem. 2019, 411, 4327–4338. [Google Scholar] [CrossRef]
- Lee, H.; Dellatore, S.M.; Miller, W.M.; Messersmith, P.B. Mussel-Inspired Surface Chemistry for Multifunctional Coatings. Science (1979) 2007, 318, 426–430. [Google Scholar] [CrossRef]
- Elbasuney, S.; El-Sayyad, G.S. Silver Nanoparticles Coated Medical Fiber Synthesized by Surface Engineering with Bio-Inspired Mussel Powered Polydopamine: An Investigated Antimicrobial Potential with Bacterial Membrane Leakage Reaction Mechanism. Microb. Pathog. 2022, 169, 105680. [Google Scholar] [CrossRef] [PubMed]
- Liu, H.; Qu, X.; Tan, H.; Song, J.; Lei, M.; Kim, E.; Payne, G.F.; Liu, C. Role of Polydopamine’s Redox-Activity on Its pro-Oxidant, Radical-Scavenging, and Antimicrobial Activities. Acta Biomater. 2019, 88, 181–196. [Google Scholar] [CrossRef] [PubMed]
- Yang, L.; Liu, X.; Zhang, X.; Chen, T.; Ye, Z.; Rahaman, S. High Performance Nanocomposite Nanofiltration Membranes with Polydopamine-Modified Cellulose Nanocrystals for Efficient Dye/Salt Separation. Desalination 2022, 521, 115385. [Google Scholar] [CrossRef]
- Picone, C.S.F.; Cunha, R.L. Chitosan–Gellan Electrostatic Complexes: Influence of Preparation Conditions and Surfactant Presence. Carbohydr. Polym. 2013, 94, 695–703. [Google Scholar] [CrossRef]
- Hoo, C.M.; Starostin, N.; West, P.; Mecartney, M.L. A Comparison of Atomic Force Microscopy (AFM) and Dynamic Light Scattering (DLS) Methods to Characterize Nanoparticle Size Distributions. J. Nanoparticle Res. 2008, 10, 89–96. [Google Scholar] [CrossRef]
- Raval, N.; Maheshwari, R.; Kalyane, D.; Youngren-Ortiz, S.R.; Chougule, M.B.; Tekade, R.K. Importance of Physicochemical Characterization of Nanoparticles in Pharmaceutical Product Development. In Basic Fundamentals of Drug Delivery; Elsevier: Amsterdam, The Netherlands, 2019; pp. 369–400. [Google Scholar]
- Nagarajan, K.J.; Balaji, A.N.; Ramanujam, N.R. Extraction of Cellulose Nanofibers from Cocos Nucifera Var Aurantiaca Peduncle by Ball Milling Combined with Chemical Treatment. Carbohydr. Polym. 2019, 212, 312–322. [Google Scholar] [CrossRef]
- Abraham, E.; Nevo, Y.; Slattegard, R.; Attias, N.; Sharon, S.; Lapidot, S.; Shoseyov, O. Highly Hydrophobic Thermally Stable Liquid Crystalline Cellulosic Nanomaterials. ACS Sustain. Chem. Eng. 2016, 4, 1338–1346. [Google Scholar] [CrossRef]
- Chaparala, V.; Ravi Kiran Sastry, G.; Phani Prasanthi, P. Thermal Degradation Study of Cotton Waste Pulp-Based Cellulose Nanocrystals. Mater. Today Proc. 2023. [Google Scholar] [CrossRef]
- Shumbula, N.P.; Nkabinde, S.S.; Ndala, Z.B.; Mpelane, S.; Shumbula, M.P.; Mdluli, P.S.; Njengele-Tetyana, Z.; Tetyana, P.; Hlatshwayo, T.; Mlambo, M.; et al. Evaluating the Antimicrobial Activity and Cytotoxicity of Polydopamine Capped Silver and Silver/Polydopamine Core-Shell Nanocomposites. Arab. J. Chem. 2022, 15, 103798. [Google Scholar] [CrossRef]
- Khan, A.; Huq, T.; Khan, R.A.; Riedl, B.; Lacroix, M. Nanocellulose-Based Composites and Bioactive Agents for Food Packaging. Crit. Rev. Food Sci. Nutr. 2014, 54, 163–174. [Google Scholar] [CrossRef]
- Gan, P.G.; Sam, S.T.; bin Abdullah, M.F.; Omar, M.F. Thermal Properties of Nanocellulose-reinforced Composites: A Review. J. Appl. Polym. Sci. 2020, 137, 48544. [Google Scholar] [CrossRef]
- Bangar, S.P.; Harussani, M.M.; Ilyas, R.A.; Ashogbon, A.O.; Singh, A.; Trif, M.; Jafari, S.M. Surface Modifications of Cellulose Nanocrystals: Processes, Properties, and Applications. Food Hydrocoll. 2022, 130, 107689. [Google Scholar] [CrossRef]
- Ryu, J.H.; Messersmith, P.B.; Lee, H. Polydopamine Surface Chemistry: A Decade of Discovery. ACS Appl. Mater. Interfaces 2018, 10, 7523–7540. [Google Scholar] [CrossRef]
- Mariano, M.; El Kissi, N.; Dufresne, A. Cellulose Nanocrystals and Related Nanocomposites: Review of Some Properties and Challenges. J. Polym. Sci. B Polym. Phys. 2014, 52, 791–806. [Google Scholar] [CrossRef]
- Trache, D.; Hussin, M.H.; Haafiz, M.K.M.; Thakur, V.K. Recent Progress in Cellulose Nanocrystals: Sources and Production. Nanoscale 2017, 9, 1763–1786. [Google Scholar] [CrossRef]
- dos Santos, F.A.; Iulianelli, G.C.V.; Tavares, M.I.B. Effect of Microcrystalline and Nanocrystals Cellulose Fillers in Materials Based on PLA Matrix. Polym. Test. 2017, 61, 280–288. [Google Scholar] [CrossRef]
- Fortelny, I.; Ujcic, A.; Fambri, L.; Slouf, M. Phase Structure, Compatibility, and Toughness of PLA/PCL Blends: A Review. Front. Mater. 2019, 6, 206. [Google Scholar] [CrossRef]

| Treatment * | Hydrodynamic Diameter (nm) | Polydispersity Index | Zeta Potential (mV) |
|---|---|---|---|
| CNC | 86.0 ± 2.19 a | 0.3 ± 0.01 a | −67.5 ± 0.87 b |
| PDA | 273.9 ± 23.06 b | 0.6 ± 0.19 b | −44.0 ± 2.55 a |
| CNC@PDA | 274.9 ± 3.27 b | 08 ± 0.04 c | −39.0 ± 1.36 a |
Disclaimer/Publisher’s Note: The statements, opinions and data contained in all publications are solely those of the individual author(s) and contributor(s) and not of MDPI and/or the editor(s). MDPI and/or the editor(s) disclaim responsibility for any injury to people or property resulting from any ideas, methods, instructions or products referred to in the content. |
© 2025 by the authors. Licensee MDPI, Basel, Switzerland. This article is an open access article distributed under the terms and conditions of the Creative Commons Attribution (CC BY) license (https://creativecommons.org/licenses/by/4.0/).
Share and Cite
Souza, A.L.d.; Oliveira, A.V.d.A.; Ribeiro, L.D.; Moraes, A.R.F.e.; Jesus, M.; Santos, J.; Oliveira, T.V.d.; Soares, N.d.F.F. Experimental and Theoretical Analysis of Dopamine Polymerization on the Surface of Cellulose Nanocrystals and Its Reinforcing Properties in Cellulose Acetate Films. Polymers 2025, 17, 345. https://doi.org/10.3390/polym17030345
Souza ALd, Oliveira AVdA, Ribeiro LD, Moraes ARFe, Jesus M, Santos J, Oliveira TVd, Soares NdFF. Experimental and Theoretical Analysis of Dopamine Polymerization on the Surface of Cellulose Nanocrystals and Its Reinforcing Properties in Cellulose Acetate Films. Polymers. 2025; 17(3):345. https://doi.org/10.3390/polym17030345
Chicago/Turabian StyleSouza, Amanda Lélis de, Arthur Vinicius de Abreu Oliveira, Laisse Dias Ribeiro, Allan Robledo Fialho e Moraes, Meirielly Jesus, Joana Santos, Taila Veloso de Oliveira, and Nilda de Fátima Ferreira Soares. 2025. "Experimental and Theoretical Analysis of Dopamine Polymerization on the Surface of Cellulose Nanocrystals and Its Reinforcing Properties in Cellulose Acetate Films" Polymers 17, no. 3: 345. https://doi.org/10.3390/polym17030345
APA StyleSouza, A. L. d., Oliveira, A. V. d. A., Ribeiro, L. D., Moraes, A. R. F. e., Jesus, M., Santos, J., Oliveira, T. V. d., & Soares, N. d. F. F. (2025). Experimental and Theoretical Analysis of Dopamine Polymerization on the Surface of Cellulose Nanocrystals and Its Reinforcing Properties in Cellulose Acetate Films. Polymers, 17(3), 345. https://doi.org/10.3390/polym17030345

